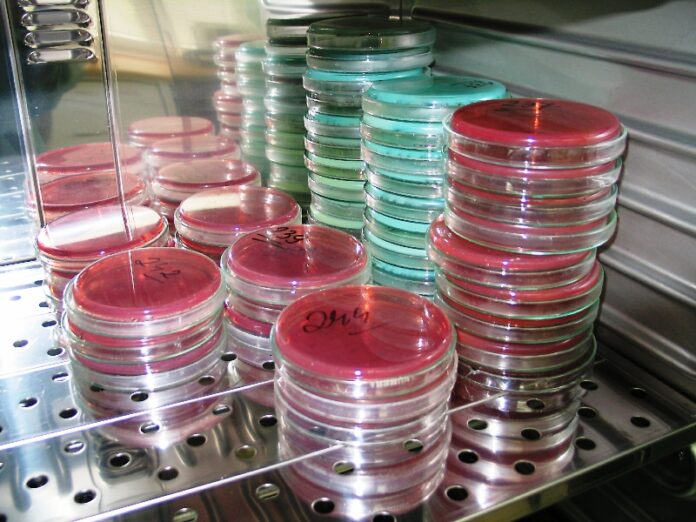
petri

El consejero de Sanidad y Asuntos Sociales, José Ignacio Echániz, ha anunciado que el próximo 6 de junio la receta electrónica será una realidad en toda Castilla-La Mancha y se ha mostrado «enormemente satisfecho» porque «el proceso de implantación» se está llevando a cabo «de una forma más ágil y rápida que en ninguna otra comunidad».
Echániz ha hecho estas declaraciones en Guadalajara durante la presentación de la implantación de la receta electrónica en la provincia, en la Farmacia de Olga Domínguez Sánchez. Guadalajara es, junto a Toledo, una de las provincias que participó en el pilotaje de este proyecto, concretamente el Centro de Salud de Sigüenza.
La implantación de la receta electrónica a toda la provincia de Guadalajara se inició el pasado 21 de marzo en el ámbito rural. Concretamente en once centros de salud: Alcolea del Pinar, Checa, Cifuentes, El Pobo de Dueñas, Horche, Maranchón, Molina de Aragón, Mondéjar, Pastrana, Sacedón y Villanueva del Alcorón, con un total de 48 farmacias con dispensación electrónica y dando cobertura a una población de 44.306 personas.
Desde esa fecha se ha ido extendiendo hasta completar la implantación en toda provincia de Guadalajara, con la incorporación de las zonas de salud y farmacias de la capital el día 24 de mayo, según ha informado la Junta en nota de prensa.
El número de recetas electrónicas en Guadalajara hasta el 24 de mayo es de 437.996, emitidas por 138 médicos a 14.365 pacientes, a quienes se han evitado un total de 113.145 desplazamientos. En esa fecha el porcentaje de implantación de la receta electrónica es del cien por cien de las Zonas Básicas de Salud y del cien por cien de las farmacias.
Durante la presentación, el consejero ha subrayado que «la implantación de la receta electrónica facilita la vida de los pacientes, a los que evitará multitud de desplazamientos innecesarios, y supone una ventaja para los profesionales de Atención Primaria, que disponen así de más tiempo para sus pacientes».